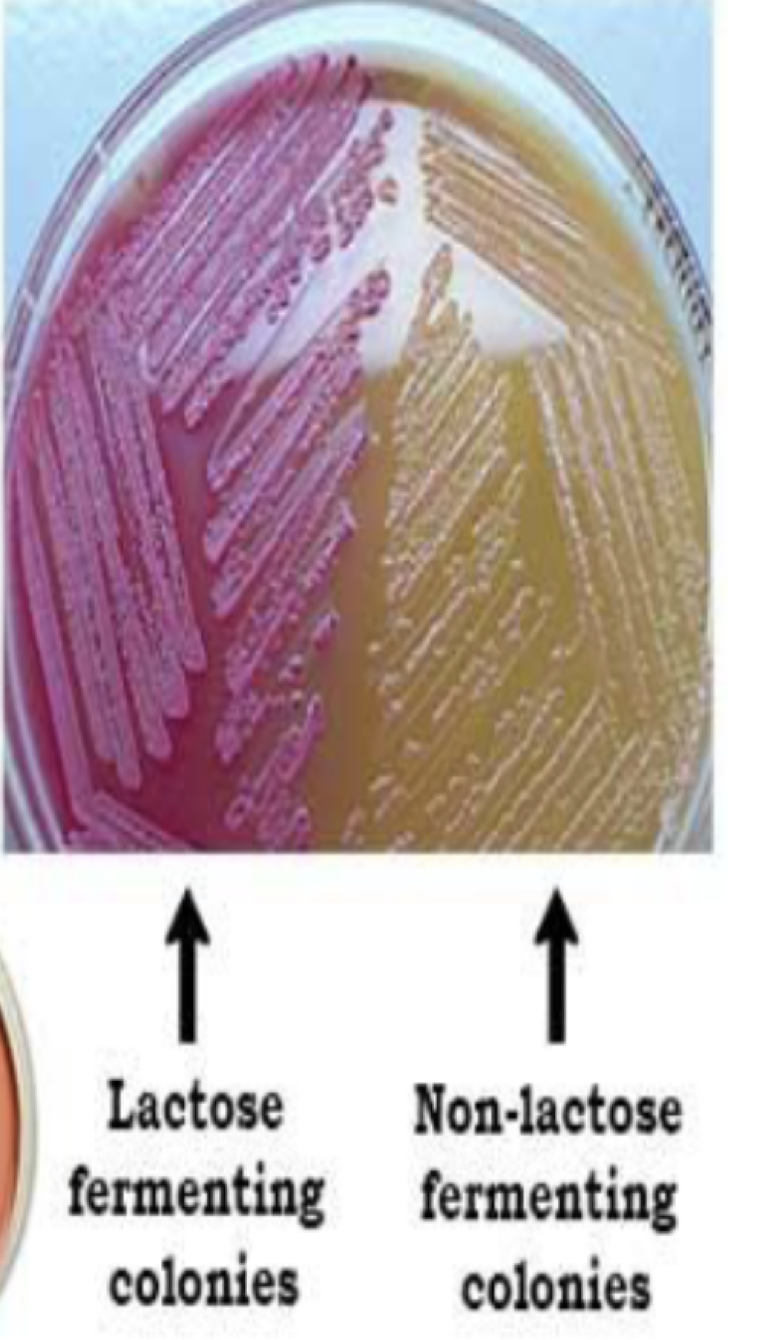
<p>Macconkey’s Agar&nbsp;</p><p>Type, what it’s used for,&nbsp;</p>
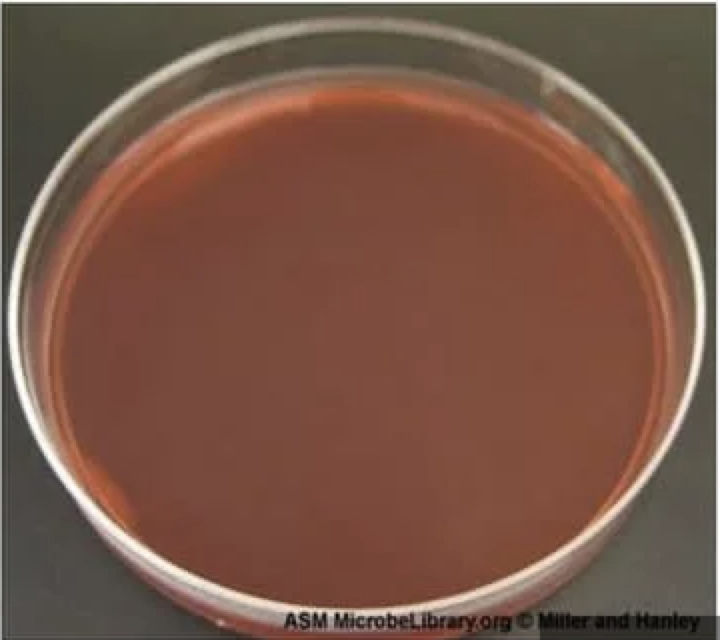
<p>What type of media is this?</p>
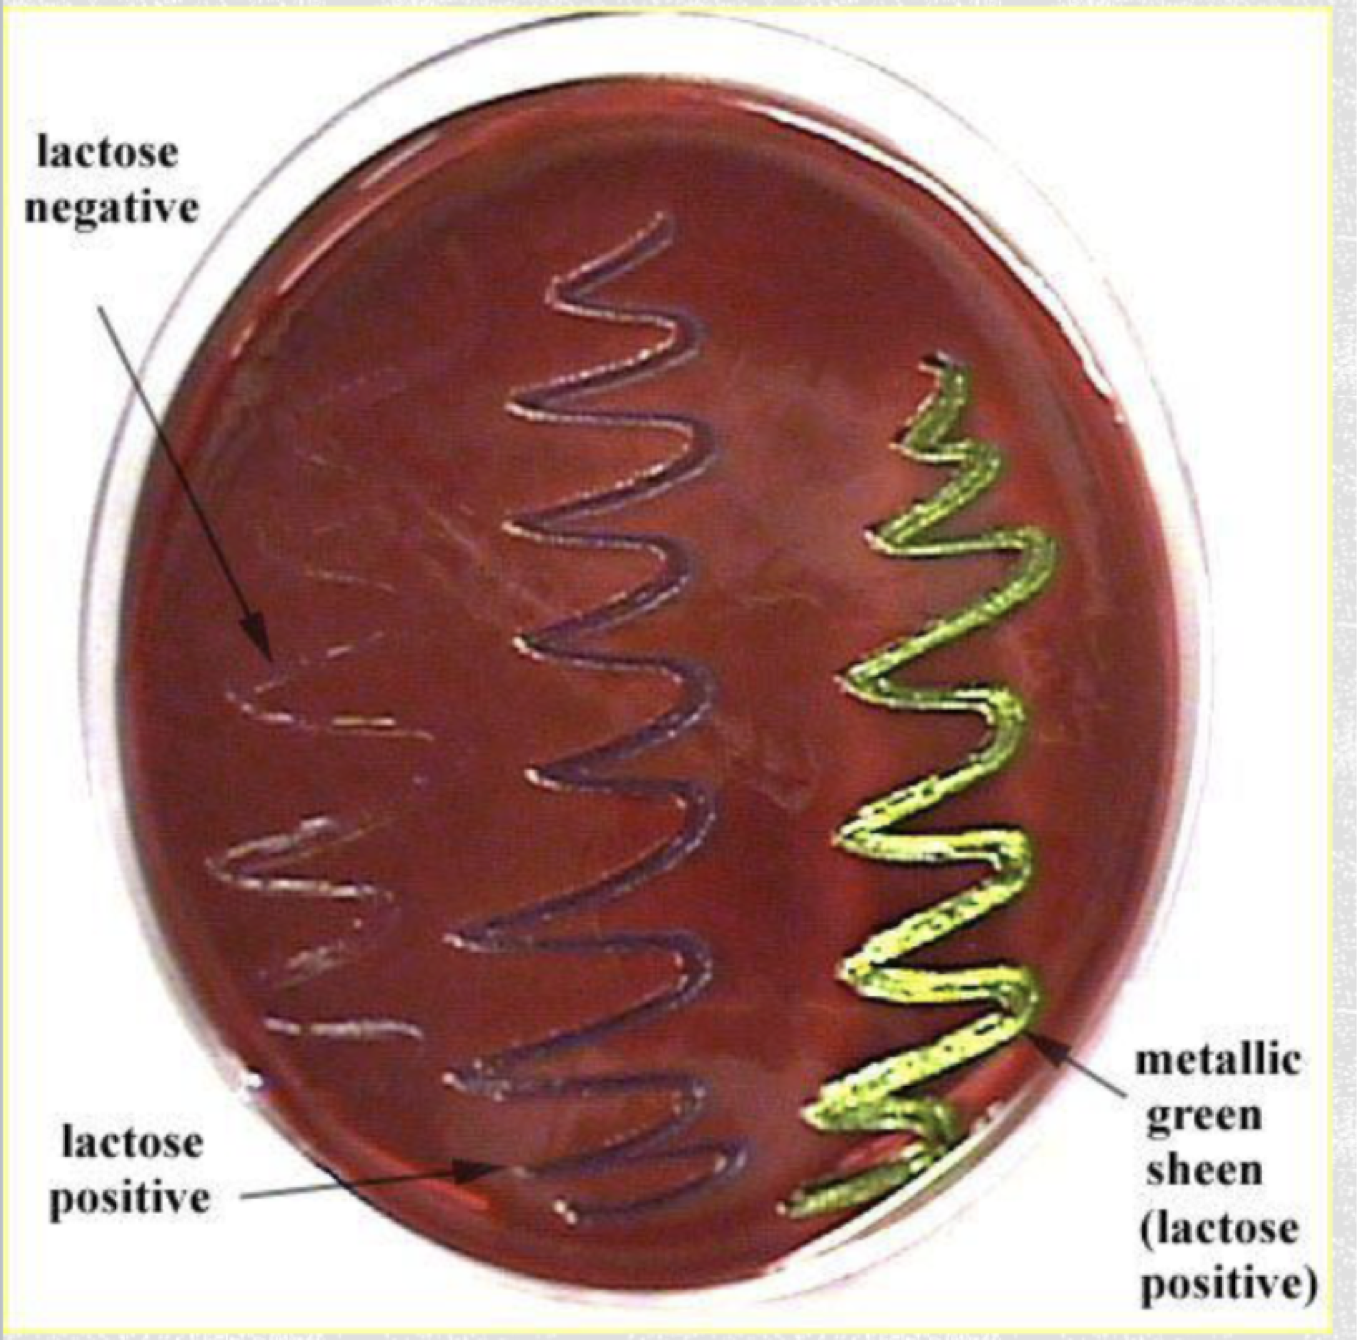
<p>Type: Selective, Differential, and Enrichment&nbsp;</p><p>Selective: Eosin Y and methylene blue are Ph indicator dyes inhibit the growth of most Gram Postive organisms (only GRAM NEGATIVE grow)</p><p>Differential: </p><p>Lactose fermenting gram negative bacteria - purple or metallic green</p><p>Slow lactose-fermenters - pink&nbsp;</p><p>Non-lactose fermenters - colorless or pink&nbsp;</p><p>Enrichment: Sucrose and lactose utilized as fermentable carbohydrates which encourage growth of some gram negative bacteria&nbsp;</p>
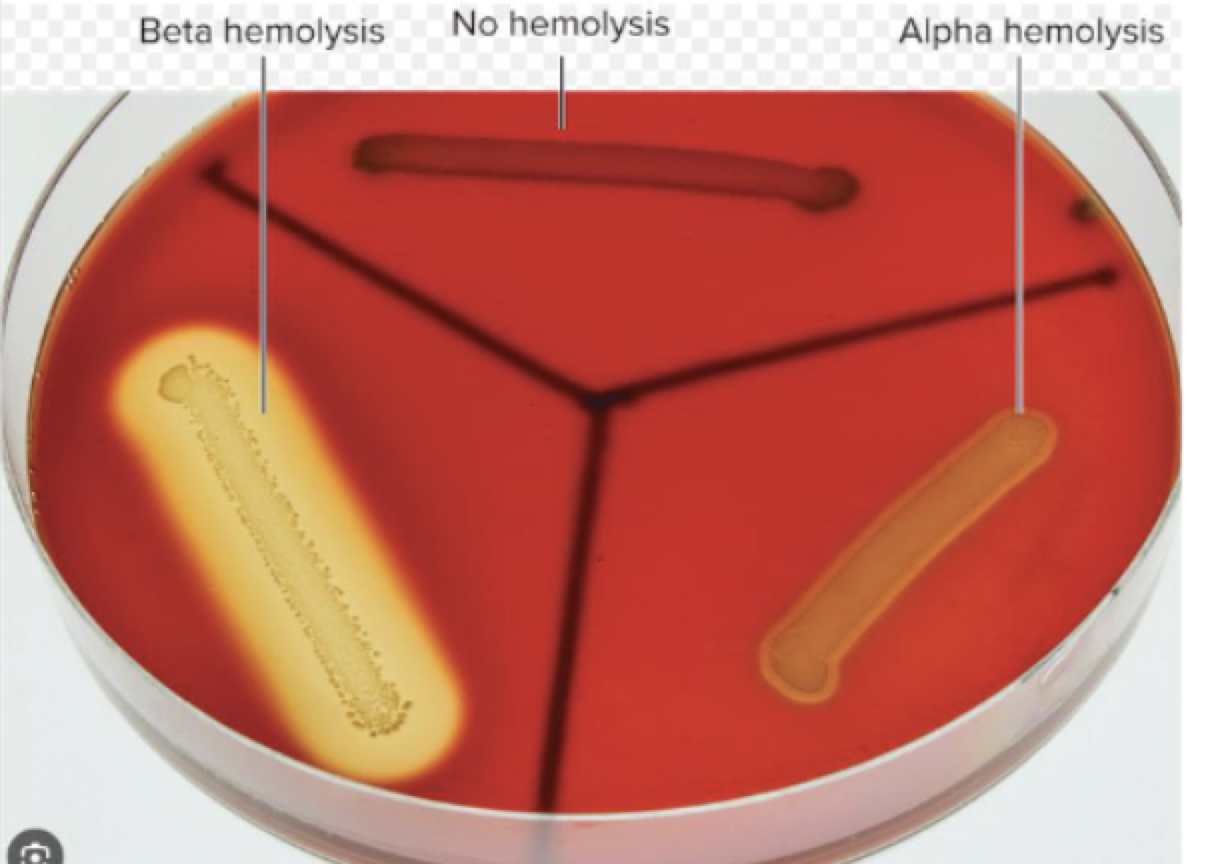
<p>Type: Enrichment and Differential </p><p>Used to culture fastidious (<span><span>microorganisms that have complex or particular nutritional requirements and are difficult to grow in a laboratory) </span></span>microorganisms and detect hemolysis </p><p></p><p>Differential: Different types of hemolysis </p><p></p><p>alpha- hemolysis: partial hemolysis, greenish opaque zone (beige)</p><p>beta-hemolysis: complete hemolysis, clear zone (ate up the RBC in agar) (bright yellow)</p><p>gamma- hemolysis: no hemolysis (dark red)</p>
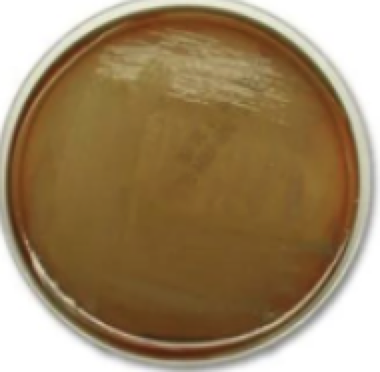
<p>What type of agar is this? </p>
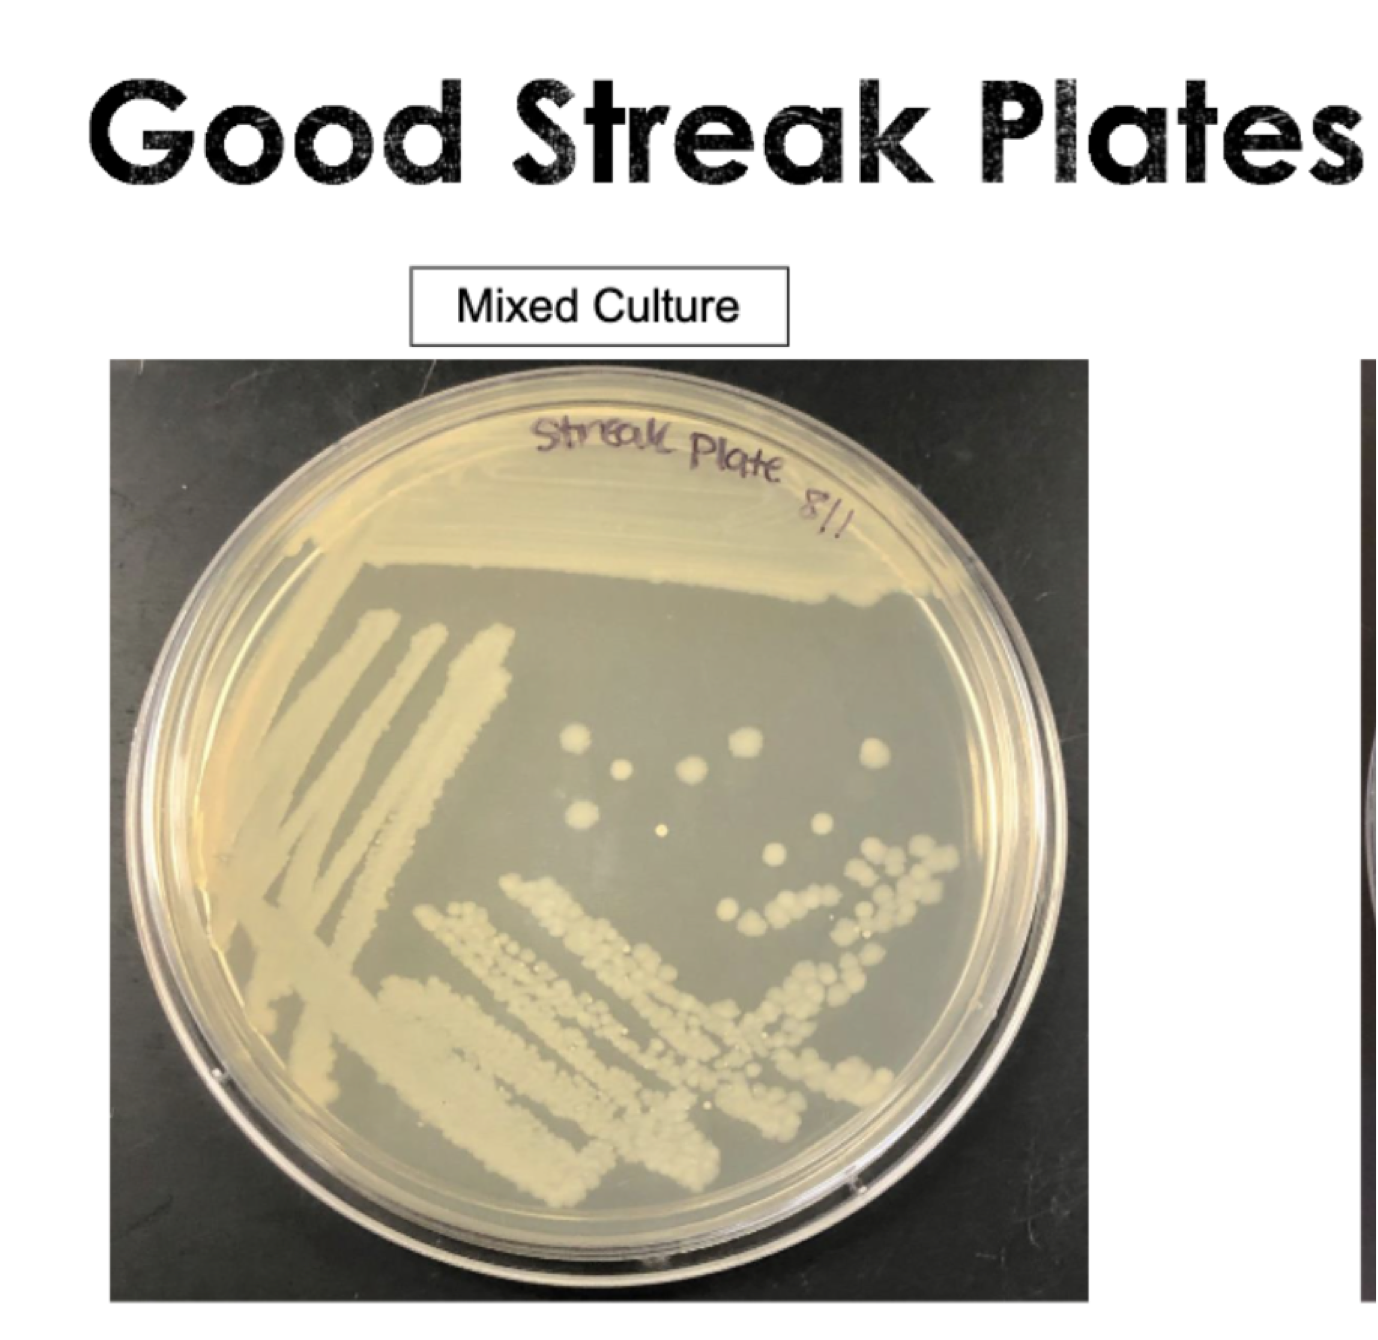
<p>To isolate bacterial colonies to obtain a PURE CULTURE bc usually bacteria are found in a mixed culture </p>
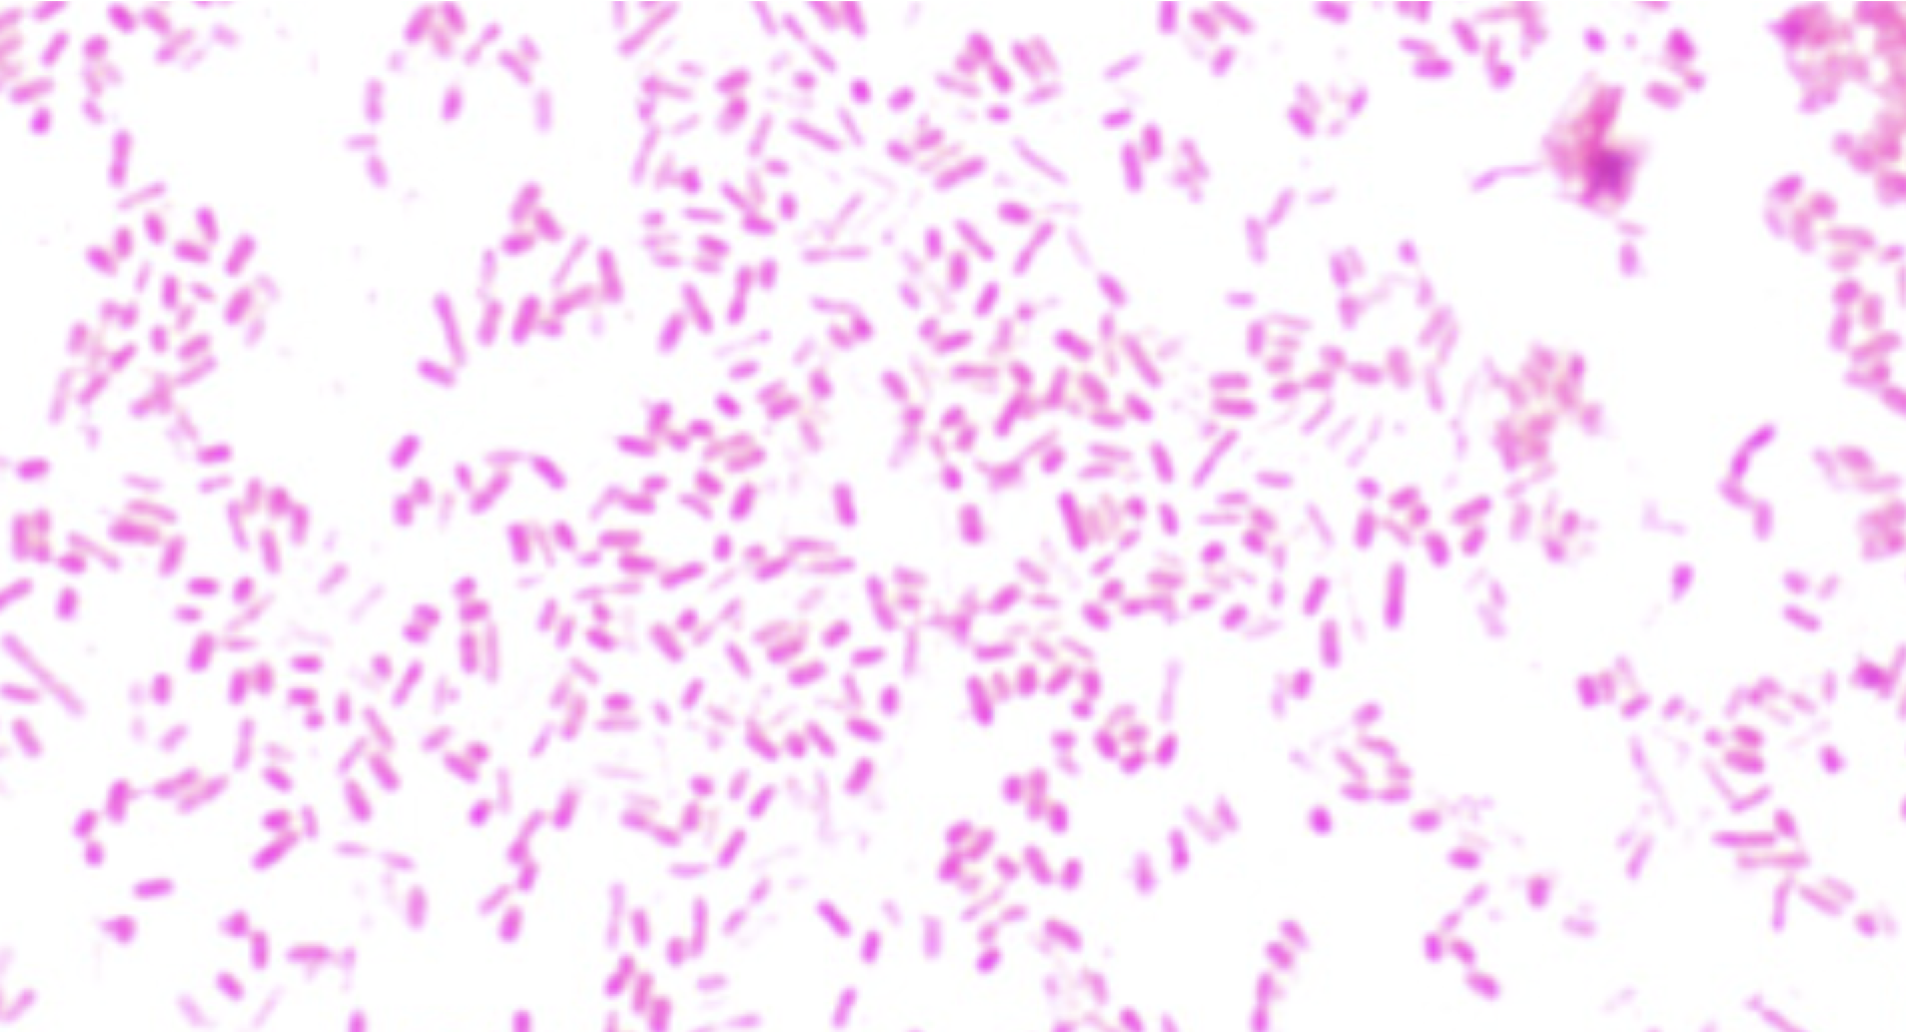
<p><span style="color: rgb(246, 246, 246);"><span>S. aureus or E. coli</span></span></p>
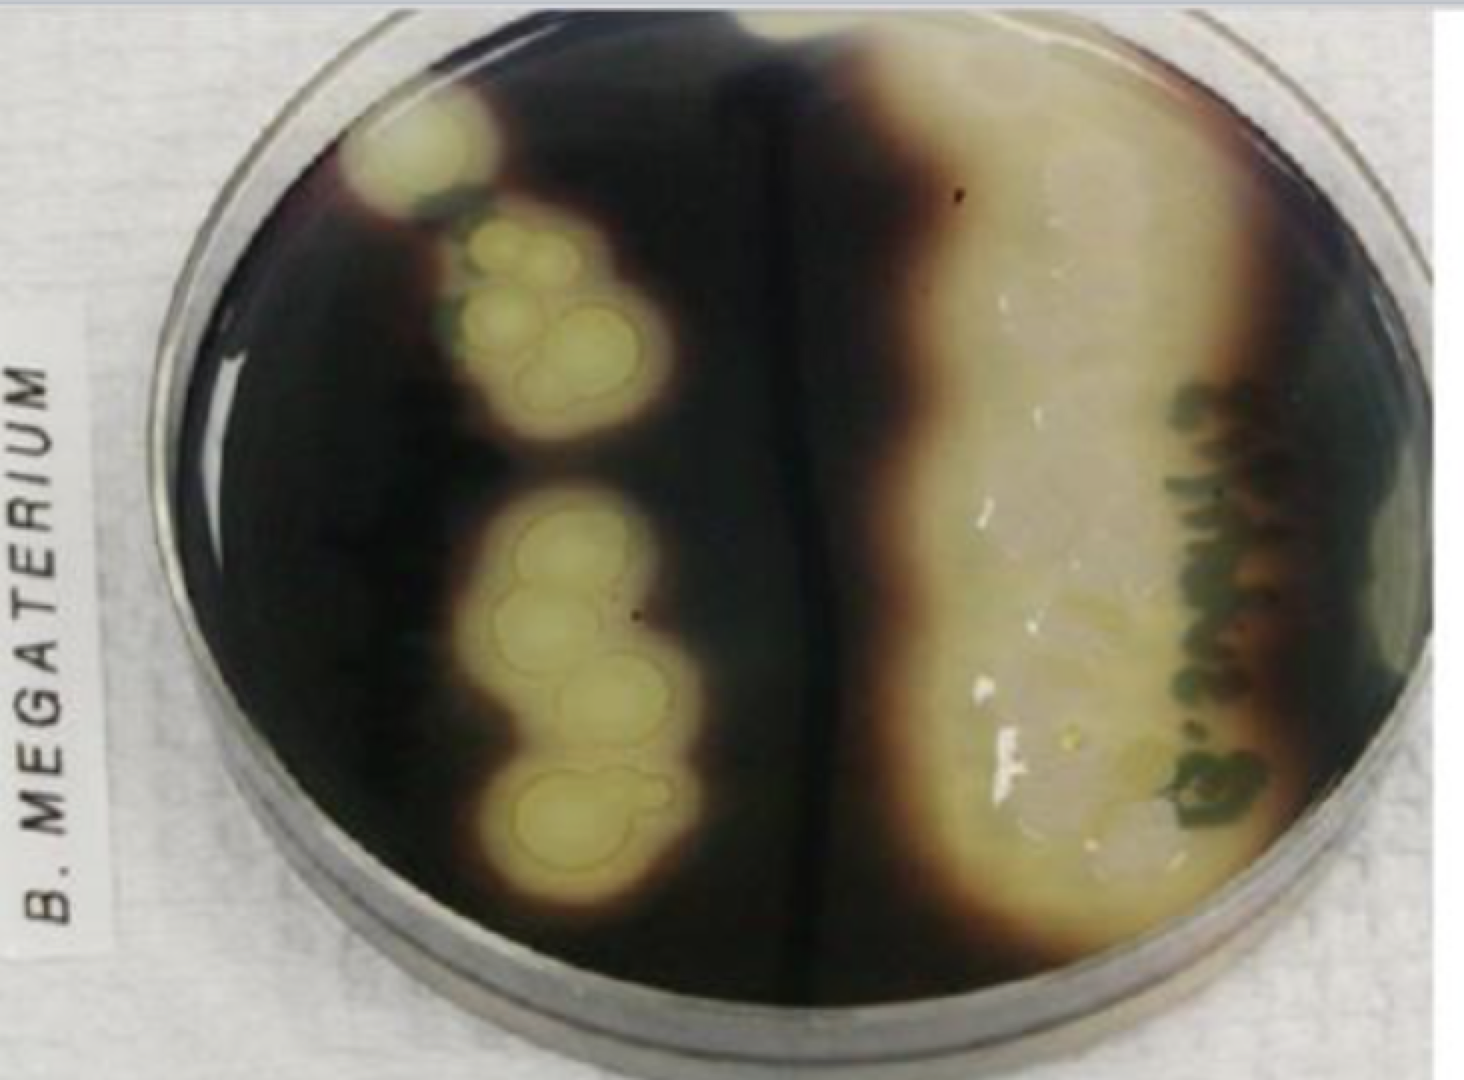
<p>tests for extracellular enzyme,s also called exoenzymes - they help break down larger macromolecules</p><p></p><p>usually Bacillus</p><p></p><p>Gram’s iodine - reacts with starch to make a dark green/ blue color, and if an enzyme present will be clear</p><p></p><p>48 hour test</p>
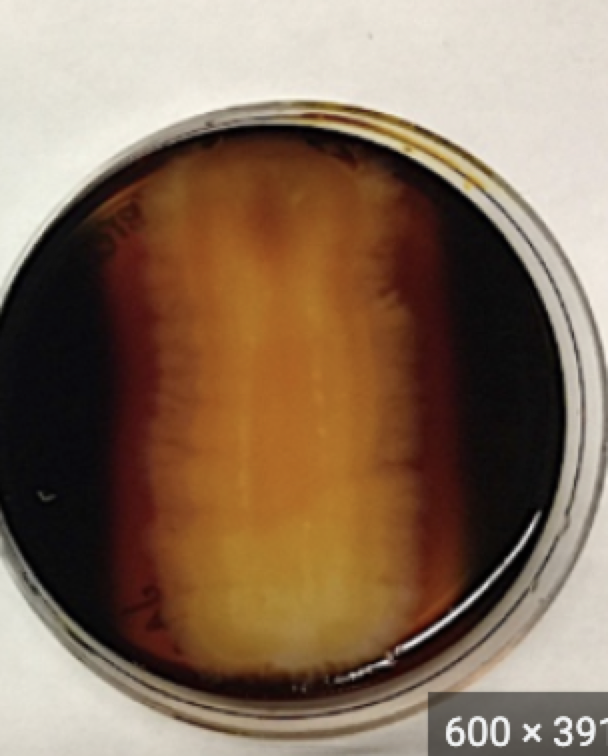
<p>What is this plate? and what does it say about the bacteria?</p>

1/134
KMS
Name | Mastery | Learn | Test | Matching | Spaced |
|---|
No study sessions yet.
Osmosis
The movement of water molecules through a selectively permeable membrane from an area of lower solute concentration to an area of higher solute concentration, aiming to equalize concentrations on both sides.
Osmotic pressure
pressure which needs to be
applied to a solution to prevent the inward flow of water across a semipermeable membrane
Hypotonic environment
Greater concentration of solute inside the cell
Hypertonic environment
Greater concentration of solute outside of the cell
Isotonic
Equal concentrations of solute inside and outside the cell
Higher salt concentration leads to
plasmolysis and cell death
plasmolysis
shrinking of protoplasm - its plasma membrane detaches from the cell wall
Halophiles
Bacteria requires high salt concentration for growth
Halotolerant
does not require a saline enviroment but can survive in one
Consequences of high PH
Breaks hydrogen bonds holding DNA together
Consequences of low PH
breaks the weak hydrogen bonds of protein side chains, changing the shape of the protein because increased hydrogen ions
Acidophile
pH 0-5.5
Neutrophile
grows best around 7pH
Alkaliphile
grows best pH 8-11.5
Antibiotic susceptibility test
determines which antibiotics
or other antimicrobial agents are effective against a specific microorganism that is causing an infection.
Kirby-Bauer method
Antibiotic diffuses from a filter paper into agar plate. If antibiotic is effective, it will inhibit bacterial growth surrounding the disk creating zone of inhibition (ZOI)
Diameter of ZOI (in mm)
determines if the organism is Resistant (R), Intermediate (I), or Susceptible (S)
When do we use Mueller-Hinton Agar and why?
Mueller-Hinton Agar :
• General growth media that supports growth of most pathogens
• Highly reproducible results
• Low in thymidine and thymine, which inhibit some antibiotics
Antiseptics
Chemicals used on live tissues to control microbial growth Ex: isopropyl alcohol, mouthwash
Disinfectants
Chemical agents that are used on inanimate objects Ex: Bleach
Fomites
objects or materials which are likely to carry infection, such as clothes, utensils, and furniture.
Cytolysis
The process where a cell swells and bursts due to an excessive influx of water.
Psychrophiles
<15 °C
Mesophiles
15 °C - 45 °C
Thermophiles
> 45 °C
hyperthermophiles
>80°C
Moist Heat
More effective than dry heat because it can penetrate microbial cells and denature proteins and melt lipids in cytoplasmic membrane
Moist heat example
Autoclave
Dry Heat
usually used to sterilize instruments.
Dry heat examples
Hot air sterilization
Thermal Death Time (Temp & time)
hortest exposure time to heat resulting in no growth after incubation at 37°C/48hr.
Effects of UV exposure
induces pyrimidine (thymine) dimers (Kink in backbone inhibits DNA polymerase activity
▪ Incorrect bases inserted to the DNA strand)
UV light is used to
steralize surfaces (short UV light) - Photoreactivation repair.
Horizontal gene transfer (name three ways)
The movement of genetic information
between organisms, a process that
includes the spread of antibiotic resistance
genes among bacteria (except for those
from parent to offspring), fueling pathogen
evolution Ex: Transformation, Conjuction, Transduction
Transformation
The process by which competent bacteria take up naked DNA from the environment.
Competent Cells
The ability of the cell to take up extracellular DNA from the environment
2 Types of Artificial Transformation
Chemical method: Calcium
chloride (CaCl2)
▪ Cells are repeatedly washed with
100 mM CaCl2 to remove all
traces of other salts (from the
growth media), then are heat-
shocked
▪ Calcium chloride is added to a
cell suspension, which promotes
the binding of plasmid DNA to
lipopolysaccharides (LPS) Physical method: Cells are repeatedly washed with a weak glycerol solution then treated with a brief electric shock, causing holes in the cell wall, through which DNA is drawn into the cell.
Plasmid ( or sex factors, conjugants, extra chromosomal replicons, or transfer factors )
Extra chromosomal DNA fragments in the cell They are double stranded structures.They can replicate independently
Structure of Plasmid (5)
Origin of replication (ori): a specific location in the strand where the replication process begins.
▪ Selective marker site: This region consists of
Antibiotic resistance genes which are useful in the identification and selection of bacteria that contain plasmids.
▪ Promoter region: Allows expression of the gene of interest
▪ Regulator: Controls expression of the gene of interest by acting on the promoter
▪ Multiple cloning sites: Insertion site for gene of interest
Gene Naming (nomenclature)
gene names are itilizised and start with lowercase letters (gfp, bia, ori), if multiple subunits - the subunit is at the end of the gene name is capalized (araC, lacZ)
Biofilms
multicellular communities held together by a self-produced extracellular matrix.
5 stages of biofilms
1.Reversible attachment: cells attach and detach from
the surface
2. Irreversible attachment: cell irreversibly attaches to
the surface via cell adhesion structures (like pili)
3. Maturation I: Slime production
4. Maturation II: the biofilm becomes encased in an
extracellular matrix
5. Release: cells within the biofilm are released.
Viable counting
A method to estimate the number of viable (alive and able to replicate) bacterial cells
in a cell suspension using serial dillution
CFU’s
Colony forming units - use CFU’s between 30-300 for counting
DF
Dilution factor - (Volume factor/total volume factor) x (DF of previous tube)
FDF
Final dilution factor = volume plated (ml) x DF of counted plate
OCD
CFU of counted plate / FDF
Spontatnous mutations
mistakes in DNA Replication, - Rate: 1 × 10^6 to 1 × 10^9
Induced Mutation
Mutations that are unnaturally forced through exposure to mutagens
Streptomycin gradient plate used for
Used for isolation of antibiotic mutations
Streptomycin gradient plate is made with
Nutrient Agar with Blue dye on the bottom slant & Streptomycin agar as top slant
Defined Media
media composed of pure ingredients in carefully measured concentrations dissolved in double distilled water
Complex Media
Rich in nutrients that contain water soluble extracts of plant or animal tissue (e.g., enzymatically digested animal proteins such as peptone and tryptone)
why and what agar
A jelly-like substance consisting of polysaccharides obtained from the cell walls of some species of red algae -used to solidify media
What temperature is the liquid state of agar.
100°C
What temperature does agar solidifies?
44°C
Autoclaving requirements
121°C for 15 minutes at 15 psi
Macconkey’s Agar
Type, what it’s used for,
Selective & Differential - used to differentiate lactose fermenting GRAM NEGATIVE bacteria from lactose non-fermenting
Selective: inhibit gram postive
Differential: Turns red below pH 6.8 (fermenting bacteria turns lactose into lactic acid )and colorless higher than pH 6.8 (non-fermenting bacteria)
What type of media is this?
MacConkey Agar

MSA (Mannitol Salt Agar) - type and what is it used for
Type: selective and Differential
Used for isolation and indentification os Staphylococcus aureus
Selective: High concentration of sodium chloride inhibits other bacterial organisms other than staph
Differential: Mannitol fermentable carbohydrate - detectable by phenol red indicator
Phenylethyl Alcohol Agar (PEA) - Type and what is it used for?
Type: Selective
Used to cultivate GRAM POSITIVE organisms
Selective: PHENYLETHYL ALCOHOL is the active ingredient that inhibits the growth of Gram-negative orgnanisms (opp of MAC agar)

Eosin Methylene Blue Agar (EMB) - type and what is it used for?
Type: Selective, Differential, and Enrichment
Selective: Eosin Y and methylene blue are Ph indicator dyes inhibit the growth of most Gram Postive organisms (only GRAM NEGATIVE grow)
Differential:
Lactose fermenting gram negative bacteria - purple or metallic green
Slow lactose-fermenters - pink
Non-lactose fermenters - colorless or pink
Enrichment: Sucrose and lactose utilized as fermentable carbohydrates which encourage growth of some gram negative bacteria
Blood agar - type and what is it used for
Type: Enrichment and Differential
Used to culture fastidious (microorganisms that have complex or particular nutritional requirements and are difficult to grow in a laboratory) microorganisms and detect hemolysis
Differential: Different types of hemolysis
alpha- hemolysis: partial hemolysis, greenish opaque zone (beige)
beta-hemolysis: complete hemolysis, clear zone (ate up the RBC in agar) (bright yellow)
gamma- hemolysis: no hemolysis (dark red)

What type of agar is this?
Blood Agar - and tells us the bacteria is alpha hemolysis - which is partial hemolysis shown by the beige color
What are endospores and what is their purpose?
Dormant structure made in the cytoplasm and they are made to protect genetic information. They also have distinct endospore locations, central, sub terminal , and terminal. When conditions are better, they will return to their vegetative state

What are the arrows pointing to?
The red is a vegetative cell and the green circle is an endospore
How do you stain an endospore?
Malachite green is used to stain the endospore and Safranin is used to stain the vegetative cell subsequently, only to GRAM POSITIVE
What are capsules?
Extracellular structures produced by bactera to allow them to adhere to surfaces, evade the immune system, protection, ect - HAVE TO DO CAPSULE STAINING (NEGATIVE STAINING)
What is negative staining?
Also known as capsule staining - use nigrosin that stains backround of slide and safranin to stain the underlying vegetative celll. - only GRAM NEGATIVE


Left to right of arrows
Nigrosin - dark purple, blue background
Vegetative cell - pink
Capsule - clear
Why use Acid fast staining? what is it?
Bacteria’s cell walls containing large amounts of waxy lipids called mycolic acid are highly resistant to normal staining techniques - You stain first with Carbol Fuchsin, which dyes the positive bacteria red, and then a counterstain with methylene blue, which shows the non-acid-fast bacteria as blue.

what stain ? what does this say about the bacteria?
Acid-fast stain
A: Positive acid-fast stain bacteria- contain large amounts of waxy lipids - MYCOBACTERIUM
B: Negative acid-fast stain bacteria - do not contain large amounts of mycolic acid
What is a colony?
A cluster of bacterial cells growing on solid media and is assumed grown from one bacterial cell
Colony morphology
Characteristics of a colony
Size
Shape
Color
Texture
Elevation
Margin
Difference between bacterial and fungal colonies
Bacterial: usually small with defined margins (edges)
Fungal: usually large with fuzzy or powdery appearance. Usually green-ish or white
Purpose of a streak plate?
To isolate bacterial colonies to obtain a PURE CULTURE bc usually bacteria are found in a mixed culture
Two types of stains are
Simple and Differential
What’s a simple stain?
Uses only one staining dye to see cells
Helps identify size, shape, and arragement of bacterial cells
what’s a differential stain ?
used two or more staining dyes to visualize cells with more than one color , can do everything of a simple + differentiate between cell types and structures
EX: Gram stain, capsule stain, endospore stain, acid-fast stain
Why and what is a Gram stain?
Differentiates bacteria based on peptidoglycan layer in cell wall,
Gram positive - thick cell wall and retain crystal violet and come out purple
Gram negative - thin cell wall and does not retain violet and counterstained pink
2 types of cell morphology (prokaryotic)
Coccus - round
Bacillus - rod shape

What stain and what does it say about the bacteria?
Gram stain with both gram positive cocci and gram negative Bacilli

What stain and what does it say about the bacteria?
Gram Stain - w/ gram postive bacilli

What stain and what does it say about the bacteria?
Gram Stain - w/ gram postive cocci

What stain and what does it say about the bacteria?
Gram stain w/ gram negative bacilli

What stain and what does it say about the bacteria?
Gram Stain w/ gram negative cocci
Name a gram postive bacteria
S. aureus, Streptococci,
Name a gram negative bacterium
E.Coli, Salmonella
S. aureus or E. coli
E.coli - pink = gram neg and Bacilli shape

S. aureus or E. coli
S. aureus - purple = gram pos and Cocci shape
Who discovered the Gram Stain?
Hans Christian Gram
What is catalase?
an enzyme that reduces HYDROGEN PEROXIDE into water and oxygen
Why can’t you use bacteria growing on blood agar for catalase test?
b/c contains RBC - form false positive
Why and what is a catalase test?
only GRAM POSITIVE - differentietes if produces enzyme catalase
add hydrogen peroxide and see bubbles
EX: Staph
what is a Starch hydrolysis test, most common bacteria, and dye?
tests for extracellular enzyme,s also called exoenzymes - they help break down larger macromolecules
usually Bacillus
Gram’s iodine - reacts with starch to make a dark green/ blue color, and if an enzyme present will be clear
48 hour test

What is this plate? and what does it say about the bacteria?
Starch hydrolysis plate - does not produce exoenzymes because dark green = negative result
What is this plate? and what does it say about the bacteria?
Starch hydrolysis plate - does produce extracellular enzymes bc light color = positive results
Why Citrate Utilization Test and what dye?
utilize citrate as a carbon source and inorganic ammonium salts as the sole source of nitrogen - if can grow will be blue and contain an enzyme citrate-permease and break down ammonia increases pH
BROMOTHYMOL BLUE pH indicator when pH is above 7.6
Green - negative = no citrate-permease, cant breakdown citrate and pH below 7.6
Blue - positive = Citrate-permease present, can breakdown citrate and pH above 7.6
24 HOUR TEST
What is a motility test
Differentiates between motile and non motile organisms - have flagella - semi solid then other media
Motile organisms reduce the colorless tetrazolium chloride (TC) to a red-colored product called formazan 24 HOUR TEST
